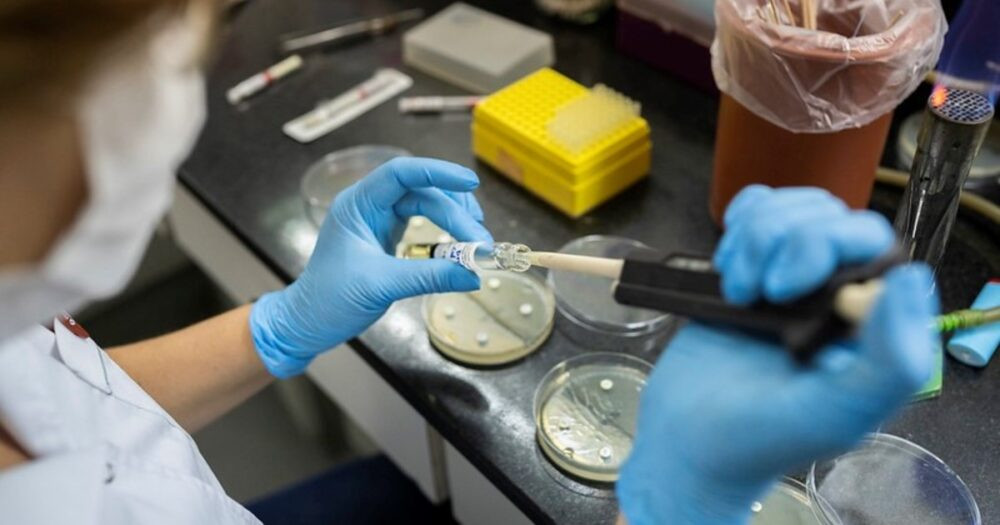

- Los adolescentes son de Santa Cruz y el niño fue internado en un hospital de la Ciudad de Buenos Aires.
- Lo confirmó el Ministerio de Salud y aseguró que los pacientes transitan la enfermedad sin complicaciones.
Los adolescentes son de Santa Cruz y el niño fue internado en un hospital de la Ciudad de Buenos Aires.Lo confirmó el Ministerio de Salud y aseguró que los pacientes transitan la enfermedad sin complicaciones. Read More